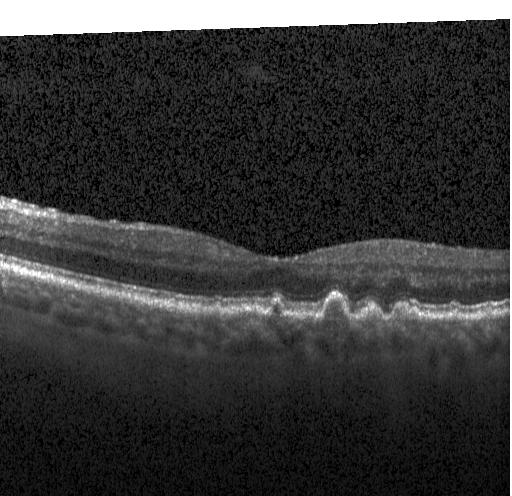

Upload 5 files
Browse files- .gitattributes +1 -0
- examples/6256161-1.jpeg +0 -0
- examples/761187-1.jpeg +0 -0
- examples/9579219-1.jpeg +0 -0
- examples/9734808-1.jpeg +0 -0
- oct_classification_final_model_lg.keras +3 -0
.gitattributes
CHANGED
|
@@ -34,3 +34,4 @@ saved_model/**/* filter=lfs diff=lfs merge=lfs -text
|
|
| 34 |
*.zst filter=lfs diff=lfs merge=lfs -text
|
| 35 |
*tfevents* filter=lfs diff=lfs merge=lfs -text
|
| 36 |
best_model_lg.Keras filter=lfs diff=lfs merge=lfs -text
|
|
|
|
|
|
| 34 |
*.zst filter=lfs diff=lfs merge=lfs -text
|
| 35 |
*tfevents* filter=lfs diff=lfs merge=lfs -text
|
| 36 |
best_model_lg.Keras filter=lfs diff=lfs merge=lfs -text
|
| 37 |
+
oct_classification_final_model_lg.keras filter=lfs diff=lfs merge=lfs -text
|
examples/6256161-1.jpeg
ADDED

|
examples/761187-1.jpeg
ADDED

|
examples/9579219-1.jpeg
ADDED

|
examples/9734808-1.jpeg
ADDED
|
oct_classification_final_model_lg.keras
ADDED
|
@@ -0,0 +1,3 @@
|
|
|
|
|
|
|
|
|
|
|
|
|
| 1 |
+
version https://git-lfs.github.com/spec/v1
|
| 2 |
+
oid sha256:12d81a936f1e622d03f4c6170acb9c8d78b4c27e85b86050e54d4598ee340c1f
|
| 3 |
+
size 118408434
|